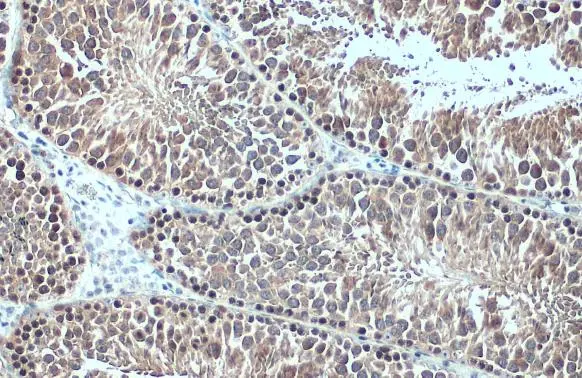
HSC70 antibody detects HSC70 protein at cytoplasm and nucleus by immunohistochemical analysis. Sample: Paraffin-embedded mouse testis. HSC70 stained by HSC70 antibody (GTX101144) diluted at 1:500. Antigen Retrieval: Citrate buffer, pH 6.0, 15

Immunohistochemical analysis of paraffin-embedded zebrafish tissue, using HSC70 antibody (GTX101144) at 1:300 dilution.
HSC70 antibody
GTX101144
ApplicationsImmunoFluorescence, Western Blot, ImmunoCytoChemistry, ImmunoHistoChemistry, ImmunoHistoChemistry Paraffin
Product group Antibodies
ReactivityHuman, Mouse, Rat, Zebra Fish
TargetHSPA8
Overview
- SupplierGeneTex
- Product NameHSC70 antibody
- Delivery Days Customer9
- Application Supplier NoteWB: 1:1000-1:20000. ICC/IF: 1:100-1:1000. IHC-P: 1:100-1:1000. *Optimal dilutions/concentrations should be determined by the researcher.Not tested in other applications.
- ApplicationsImmunoFluorescence, Western Blot, ImmunoCytoChemistry, ImmunoHistoChemistry, ImmunoHistoChemistry Paraffin
- CertificationResearch Use Only
- ClonalityPolyclonal
- Concentration1.37 mg/ml
- ConjugateUnconjugated
- Gene ID3312
- Target nameHSPA8
- Target descriptionheat shock protein family A (Hsp70) member 8
- Target synonymsHEL-33, HEL-S-72p, HSC54, HSC70, HSC71, HSP71, HSP73, HSPA10, LAP-1, LAP1, NIP71, heat shock cognate 71 kDa protein, LPS-associated protein 1, N-myristoyltransferase inhibitor protein 71, constitutive heat shock protein 70, epididymis luminal protein 33, epididymis secretory sperm binding protein Li 72p, heat shock 70kDa protein 8, heat shock 70kd protein 10, heat shock cognate protein 54, heat shock protein family A member 8, lipopolysaccharide-associated protein 1
- HostRabbit
- IsotypeIgG
- Protein IDP11142
- Protein NameHeat shock cognate 71 kDa protein
- Scientific DescriptionThe product encoded by this gene belongs to the heat shock protein 70 family which contains both heat-inducible and constitutively expressed members. The latter are called heat-shock cognate proteins. This gene encodes a heat-shock cognate protein. This protein binds to nascent polypeptides to facilitate correct folding. It also functions as an ATPase in the disassembly of clathrin-coated vesicles during transport of membrane components through the cell. Two alternatively spliced variants have been characterized to date. [provided by RefSeq]
- ReactivityHuman, Mouse, Rat, Zebra Fish
- Storage Instruction-20°C or -80°C,2°C to 8°C
- UNSPSC41116161